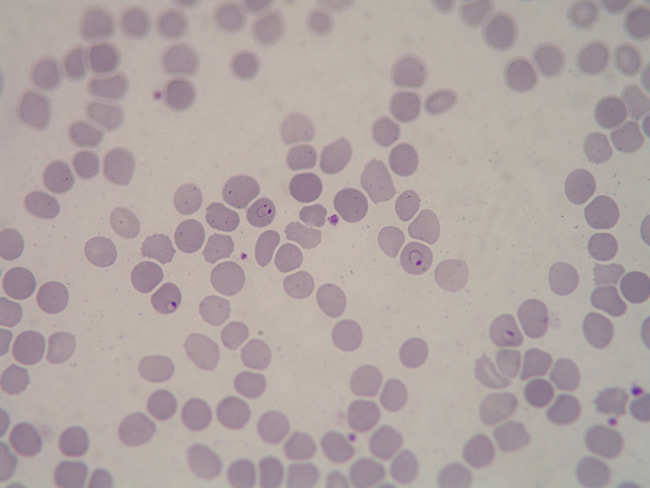

Un
caso di malaria da Plasmodium Falciparum
Clinica
Pediatrica e *U.O. Emato-oncologia, IRCCS Burlo Garofalo, Università
di Trieste.
Indirizzo
per corrispondenza: patarino@yahoo.it
Keywords:
P. Falciparum, thin blood smear, mefloquine.
Summary:
we report a case of falciparum malaria in a 2 years old boy, from
Burkina Faso. The diagnosis was made by anamnesis, clinical
presentation and thin blood smear features. The prevalence of
cloroquine-resistence in Burkina Faso is elevated, thus the therapy
was made with 2 doses of mephloquine, according to the most recent
guidelines.
F. è
un bambino di 2 anni e 8 mesi, proveniente dal Burkina Faso, in
Italia da circa 10 giorni, dalla cui anamnesi patologica remota
emerge il riscontro, nell'aprile 2004, di un'anemia microcitica.
Mentre
era ancora nel suo paese d'origine, due settimane prima che
giungesse alla nostra osservazione, ha presentato un primo episodio
febbrile notturno con temperatura fino a 38.5°C non accompagnato
da altri sintomi; gli esami eseguiti il giorno seguente mostravano
un'importante anemia microcitica (GR 3600000, Hb 7.8 gr/dl, MCV
69); in quell'occasione venivano riferiti dalla mamma frequenti
episodi di sudorazione, verificatisi nei giorni successivi alla
puntata febbrile, non accompagnati da febbre.
Il
piccolo è stato poi sostanzialmente bene per una decina di
giorni, quando ha presentato un episodio febbrile notturno con
temperatura fino a 38.2°C, seguito, la mattina successiva, da un
episodio di vomito; è rimasto poi sfebbrato fino al giorno
successivo quando ha avuto un nuovo picco pomeridiano fino a 38.2°C.
Per tale motivo è stato portato all'ospedale locale, dove
gli accertamenti mostravano un'anemia microcitica importante (Hb
5.9 gr/dl, MCV 65) con segni di emolisi (Bil tot 1.6 con Bil dir.
0.2, LDH 908, tracce di emoglobina all'esame urine) ed un aumento
degli indici di flogosi (VES 120, PCR 9.9). Da questi esami,
considerati anche l'origine del bambino e l'andamento della
febbre, è stato posto il sospetto di malaria e il piccolo
veniva trasferito presso la nostra clinica pediatrica.
All'ingresso
F. si presentava prostrato, con mucose e cute palmare pallide,
anitterico. Dall'esame obiettivo sono emerse una moderata
tachicardia (F.C. 154), ed un addome globoso con un'importante
epato-splenomegalia (fegato e milza rispettivamente a 4 cm e 15 cm
dall'arcata costale). Il piccolo presentava ancora febbre (TC
39.9°C). Gli esami eseguiti all'ingresso sono risultati del
tutto compatibili con il quadro infettivo e di emolisi in corso:
emocromo: Hb 6.4 gr/dl, MCV 68, Htc 20, PLT130000; indici di flogosi
elevati (PCR 25.6, VES); AST 60 ALT 22, IgG 1502, bilirubina tot 1.71
(diretta 0.05); urine color marsala (allo stix: urobilinogeno: 2-4
mg/dl e bilirubina ++).
Viste
l'importante anemia, la discreta tachicardia del bambino e la
possibilità di nuovi episodi di emolisi è stata
effettuata una trasfusione con emazie concentrate ed è stato
supportato con soluzione glucosata come profilassi delle eventuali
ipoglicemie secondarie all'infezione.
Dallo
striscio periferico (Figure
1,2) è emersa la presenza di parassiti all'interno degli
eritrociti (parassitemia 2-3/campo) con un aspetto che ha fatto
pensare al Plasmodium Falciparum.
Confermata
quindi l'ipotesi di malaria la notte stessa è stata avviata
terapia con Meflochina essendo la zona di provenienza del piccolo
segnalata come clorochino-resistente; sono state somministrate 2 dosi
a distanza di 12 ore, la prima pari a 16,5 mg/Kg, la seconda a 10
mg/Kg, entrambe precedute da metoclopramide.
Nell'arco
di circa 36 ore il bambino si è sfebbrato e ha ripreso ad
alimentarsi da solo.
Dopo 3
giorni di ricovero il bambino è stato dimesso, in buone
condizioni generali, con terapia di supporto per l'emolisi (acido
folico).
Ad un
controllo effettuato presso l'ospedale di riferimento 10 giorni
dopo la dimissione, i valori di laboratorio e l'obiettività
sono risultati nella norma.
La
malaria è una malattia che nel mondo occidentale sta assumendo
una rilevanza clinica sempre maggiore, visti il crescente fenomeno
dell'immigrazione e i viaggi sempre più numerosi in aree
endemiche1-3; è una diagnosi che va sempre pensata di fronte
ad un paziente con febbre ed anamnesi di un viaggio recente in zone a
rischio, anche se è stata eseguita una profilassi. La presenza
di splenomegalia ed anemia aumentano il sospetto clinico. Lo striscio
ematico con ricerca del parassita è l'esame diagnostico4 .
Una diagnosi tempestiva è fondamentale per poter impostare una
terapia adeguata, tenendo conto dell'area di provenienza del
paziente che ci darà un'indicazione sia sul tipo di
Plasmodio coinvolto sia sulla sua eventuale resistenza alla
clorochina. Nel caso della malaria da P. Falciparum, la
diagnosi costituisce un'emergenza medica, dato che questa è
la forma più severa ed associata ad una parassitemia intensa;
in assenza di una terapia tempestiva ed adeguata, la mortalità
tra i bambini non immuni arriva fino al 30%.5
Nel
nostro caso il paziente proveniva dal Burkina Faso, area in cui è
diffuso il Plasmodium Falciparum, e l'eziologia è
stata confermata dallo striscio periferico, da cui sono emerse le sue
caratteristiche tipiche6 (più di un parassita per GR, doppio
corpo di cromatina, assenza di granulazioni intraeritrocitarie)
(Figura 1,2). Nell'area di origine del piccolo è inoltre
segnalata, da molto tempo, la presenza di numerosi ceppi diPlasmodium Falciparum clorochino-resistenti7 ed è stato
quindi necessario attuare una terapia con un farmaco alternativo.
Abbiamo deciso di utilizzare la meflochina, essendo un farmaco
facilmente disponibile, che può essere somministrato per bocca
e per un periodo più breve rispetto ad altri farmaci8,9. Le
più recenti linee guida indicano che la dose ottimale è
di 25 mg/kg, da somministrare in due dosi separate, a distanza di 12
ore10. Con questa terapia si ottiene la completa guarigione, senza
successive ricadute, e non è necessario ricorrere ad ulteriori
trattamenti antiparassitari; inoltre, la doppia dose riduce
significativamente gli effetti collaterali (che invece erano più
frequenti con la monosomministrazione)11-13. C'è però
da segnalare, che, data la lunga emivita del farmaco (21 giorni), è
possibile che gli effetti collaterali, quando presenti, si
verifichino entro le 3 settimane successive alla terapia.
In
conclusione, un caso di malaria da Plasmodium Falciparum, che
poteva essere grave, data l'età del piccolo e trattandosi
verosimilmente di una prima infezione, è stato gestito
facilmente e in tempi accettabili grazie ad una tempestiva diagnosi.
La diffusione anche presso le nostre realtà di patologie un
tempo considerate tropicali deve comportare un'adeguamento delle
conoscenze mediche in quest'ambito, per garantire un'assistenza
ottimale. Si pone il problema se i primo episodio fosse di malaria.
Pensiamo di no. Il valore di Hb di 7,8 mg/dl è comune nei
bambini africani; la malaria da Plasmodium Falciparum non ha e
non può avere un andamento bifasico, a meno di un trattamento
iniziale inadeguato: l'esordio emolitico è comune nella prima
infezione.
- 1. Stevenson JE, MacLean JD Imported malaria: clinical presentation and examination ofsymptomatic travellers Arch Intern Med 1995;155:861-868.
- 2. Kain KC,. Harrington MA Imported malaria: prospective analysis of problems in diagnosis and management Clin Infect Dis 1998; 27:142-149.
- 3. Greenwood B, Mutabingwa T Malaria in 2002 Nature 2002 Feb 7;415(6872):670-2.
- 4. Stauffer W,. Fischer PR Diagnosis and treatment of malaria in children Clinical Infectious Disease 2003;37:1340-1348.
- 5. Malaria (Plasmodium). In Behrman RE, Kliegman RM, Jenson HB (Editors): Nelson Textbook of Pediatrics 17th edition, Philadelphia, Pennsylvania 2004, pag.1139-1143.
- 6. In Moroni M, Esposito R, De Lalla F (Editori): Manuale di malattie infettive 4a edizione, Milano, Italia 1996, pag. 603-615.
- 7. Del Nero L, Lamizana L Sensitivity to antimalarial drugs by Plasmodium falciparum in Goundry, Oubritenga province, Burkina Faso Parassitologia 1994;36(3):287-93.
- 8. In Larry K (Editor):Red book: Report of the committee on infectious disease 26th edition by American Academy of Pediatrics, Elk Grove Village 2003, pag 343-347.
- 9. Dubos F, Dellatre P Efficacy and tolerance of mefloquine in the treatment of infants and children with Plasmodium falciparum malaria Arch Pediatr 2003 Jan;10(1):25-30.
- 10. In Gilbert DN, Moellering RC, Sande MA The Sanford guide of antimicrobial therapy. Hyde Park, VT: Antimicrobial Therapy 2002.
- 11. Dubos F, Dellatre P Safety of mefloquine in infants with acute falciparum malaria
- Pediatr Infect Dis J 2004;23(7):679-81.
- 12. Luxemburger C, Price RN Mefloquine in infants and young children Ann Trop Paediatr1996;16(4):281-6.
- 13. Kuile FO, Nosten F Mefloquine treatment of acute falciparum malaria: a prospective study of non-serious adverse effects in 3673 patients Bull World Health Organ 1995;73(5):631-42.
Figura
1: striscio periferico in cui si osservano due globuli rossi con
all'interno il Plasmodio ad anello; la freccia indica il Plasmodio
con doppio corpo di cromatina, tipico del P. Falciparum.

Figura
2 : striscio periferico con presenza di numerosi globuli rossi
con all'interno plasmodi, di cui uno con doppio corpo di cromatina.